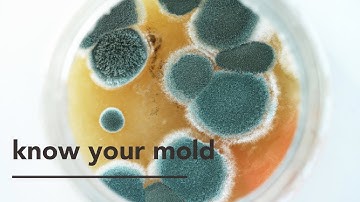
Trichoderma Fungi: Some Surpising Facts

⬇ DOWNLOAD NOW
Kalau muncul iklan pop-up, tutup lalu klik tombol kembali
Download lagu How do Trichoderma work? Atens explain it to you secara gratis hanya untuk keperluan promosi. Dukung artis favorit kamu dengan membeli musik original di iTunes atau platform resmi lainnya.
 Trianum (Trichoderma harzianum) - How does it work?
Trianum (Trichoderma harzianum) - How does it work?
 Neutrog TV | What is Trichoderma and what can it do for your garden? + GOGO Juice
Neutrog TV | What is Trichoderma and what can it do for your garden? + GOGO Juice
 What is trichoderma viride??? #Gardenhackssouravmondal
What is trichoderma viride??? #Gardenhackssouravmondal
 What is Trichoderma
What is Trichoderma
 Trichoderma harzianum T22 combats Fusarium in maize roots – Koppert
Trichoderma harzianum T22 combats Fusarium in maize roots – Koppert
 Trichoderma Introduction & Function
Trichoderma Introduction & Function
Trichoderma Fungi: Some Surpising Facts
Trichoderma Fungi: Some Surpising Facts
 Benefits of Farming with Biologicals- Bradyrhizobia & Trichoderma
Benefits of Farming with Biologicals- Bradyrhizobia & Trichoderma